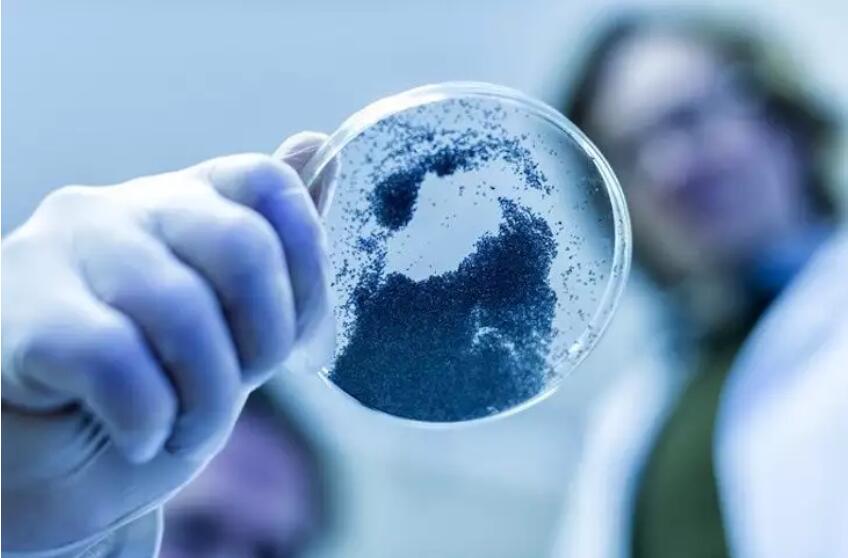

“我国新材料产业要进入世界发展前列,不仅需要有一批世界一流的创新型企业、科研院所,而且需要有一批能走上国际舞台的测试服务机构,只有这样才能真正占领国际新材料产业发展高地。”
“对任何一种新材料而言,如果没有足够的、有说服力的测试评价数据支持,产品的推广应用就无从谈起。”
………
9月7日,《中国冶金报》记者在由工业和信息化部、黑龙江省人民政府主办的第五届中国国际新材料产业博览会·中国新材料测试评价联盟大会暨关键战略性新兴产业领域新材料测试评价技术高峰论坛上了解到,国家正在全力推进新材料产业发展和测试评价体系建设,加快发展新材料产业。

新材料产业创新发展体系逐步优化
新材料产业是新一轮科技革命和产业变革的基石与先导,是世界各国科技经济竞争的焦点领域。党中央、国务院高度重视新材料产业发展。2016年12月,国务院成立了国家新材料产业发展领导小组(以下简称领导小组)。领导小组成立后,建立了部门统筹、协同联动的工作机制,开展了类型各异、功能互补的载体建设,积极促进产品推广应用、市场培育,不断夯实统计标准、引导目录等行业管理基础。
为解决新材料生产应用衔接空缺问题,领导小组启动了国家新材料生产应用示范平台建设,通过“一个平台解决一系列材料生产应用问题”。据介绍,2017年,已经启动航空材料、核能材料、航空发动机材料生产应用示范平台建设,2018年还将启动汽车轻量化材料、集成电路材料、高技术船舶和海工装备材料等重大应用领域的平台建设工作。
为解决新材料测试评价体系分散、测试设备忙闲不均、测试结果无法互认等问题,领导小组分“主中心、行业中心、区域中心”推进新材料测试评价平台建设。目前,相关中心已经陆续落地,新材料测试评价体系正在逐步形成。

为解决新材料“信息孤岛”问题,领导小组启动了新材料产业资源共享平台建设,将利用新一代信息技术,加快产业资源交流互通,提升行业管理水平和公共服务能力。
为解决数据积累与优化、共性技术产出和应用等问题,领导小组开展了新材料参数库平台、新材料制造业创新中心等建设。
会议强调,促进新材料推广应用是当前的工作重点。为此,领导小组建立了新材料首批次应用保险补偿机制,并启动试点;加大重点新材料产品的生产应用支持力度,加快推动新材料技术创新成果向市场应用转化;积极组织重点企业与行业协会,建立上下游合作机制,促进产业链协同创新和高效应用;重视新材料军民融合发展,加快推动碳纤维、高强钢等军民共用新材料产业化、规模化应用。
为科学界定新材料发展阶段,实现分类施策、精准支持,领导小组制定了《新材料技术成熟度等级划分及定义》国家标准;为突出抓好新材料产业标准化工作,完善新材料产业标准体系,发布了《新材料标准领航行动》;为统筹配置资金、项目、政策等产业资源,开展了重点新材料企业、重点产品、重点集聚区目录编制;为进一步明确新材料产业边界与范围,修订了战略性新兴产业分类目录中的新材料部分内容,开展了新材料产业统计监测摸底。
测试评价工作是我国新材料产业发展的关键环节
测试评价贯穿新材料研究开发、生产制备、应用服役全过程,是新材料产业发展的重要环节,是衡量材料性能、使用效果和真正价值的关键手段。加快推进新材料测试评价工作,加快提高材料性能质量,是加快建设制造强国、加快发展先进制造业的迫切需要。
会议介绍,通过加强测试评价工作,可以实现“四个有助于”:
一是有助于解决“测不准、不会测”等难题,系统提升行业技术服务水平。加强测试评价工作,就是要擦亮新材料产业发展的“眼睛”,优化物理化学性能、组织结构特征等传统测试技术,完善新材料的服役性能、应用评价、寿命预测等方面测试评价方法、装备和手段,提升测试评价效率、准确性和服务水平。
二是有助于整合测试资源,形成高效协同的工作体系。通过建立联盟、搭建平台等方式,将原本分散在不同行业、区域和主体中的测试评价仪器设备资源高效整合共享,解决测试设备重复投入,先进仪器设备忙闲不均,测试机构竞争多而合作少等问题。在这方面,新材料测试评价联盟已经开展了很多工作,利用信息共享库帮北京化工大学、中船12所、上海华谊、电子五所等多家单位的测试需求实现了快速对接,取得了良好成效。
三是有助于推动数据积累共享,支撑新材料开发应用模式创新。测试评价是一个与数据密切相关的工作。测试评价单位在服务过程中会产生大量数据。但是,一些单位对测试评价数据重视不够,管理不规范,数据可溯性、对比性不强。各单位之间数据标准不统一,导致数据大多只是局限在内部使用,难以实现交互共享,大量具有潜在应用价值的数据未能得到充分利用,“数据金矿”未能充分开发。为此,必须在新材料测试评价领域,建立规范的数据收集、整理、共享、挖掘机制,为我国新材料产业的快速发展提供保障。
四是有助于培育一批龙头测试机构,形成权威的第三方服务能力。目前,全球范围内大型综合性测试机构基本上来自欧美等发达国家和地区。我国在这方面起步较晚,尚未形成在国际上具备较强影响力的第三方机构,不利于我国新材料产业进入世界发展前列。据统计,国内现有测试机构约1.6万家,平均每家从业人数不足30人,82%以上的测试评价机构仅在所在省份提供服务,提供全国性服务的机构数量偏少,国际化发展的机构几乎没有。因此,我们要推动发展一批龙头测试机构,形成健全的、市场化的第三方测试评价体系。
新材料测试评价工作总体思路和平台建设安排
2017年,工业和信息化部联合发展改革委、科技部、财政部研究编制了《新材料产业发展指南》,提出要强化新材料产业协同创新体系建设,特别是明确了测试评价工作的相关部署,总的思路是以新材料产业发展需求为导向,组织重点新材料研发机构、生产企业和计量测试技术机构建立中国新材料测试评价联盟;采取市场化机制整合完善现有测试评价资源构建国家新材料产业测试评价平台;发挥联盟和平台两方面作用,联合新材料产业上下游企业、科研院所,完善我国新材料测试评价体系,即建成“一个联盟、一个平台、一套体系”。
会议介绍,测试评价平台区别于联盟等相对松散的组织形式,是采取独立法人运作的实体化机构,是新材料测试评价体系的重要载体,是当前一段时间新材料测试评价工作的重中之重。落实到具体建设上,要按照主中心、行业中心、区域中心等3类中心来统筹推进。
主中心是平台的核心部分,是整个平台的中央处理器(CPU),承担着平台的业务、数据等调度统筹工作,并负责开展共性测试评价技术、方法开发,以及大型共性测试评价设施的建设等工作。2017年,通过公开招标明确了主中心的建设任务由北京有色院国合通测公司承担。行业中心围绕新材料产业发展的重要领域进行建设,是该行业的权威测试评价机构,主要承担所属行业新材料测试评价技术开发和对外服务职能。大体上在每个重点行业只建1个行业中心,每个中心都要针对所属行业特定新材料品种,完善专用测试能力,形成符合行业特点和下游需求的测试评价条件。2017年,钢铁新材料、电子材料行业中心已经启动,2018年还将布局稀土新材料、无机非金属新材料中心。到2020年,我们将在先进基础材料、关键战略材料和前沿新材料等领域布局行业中心。区域中心主要是解决区域内新材料测试评价问题,服务于该区域新材料产业发展。区域中心将在今年正式启动,在未来2-3年内持续推进建设,逐步形成若干体现我国新材料产业集聚特点、符合地方新材料产业发展优势和前景的区域中心。区域中心的建设将实行“成熟一个、建设一个”,有条件的地区可以先推进地方性中心建设,时机成熟后再融入国家平台这个大网络。
关于新材料测试评价平台建设工作,会议指出,总的目标是到“十三五”末,完成国家新材料测试评价平台总体布局,初步形成测试评价服务网络体系,到2025年,基本形成覆盖全国主要新材料产业集聚区和上下游市场的测试评价体系。
目前,各类中心正在紧锣密鼓地推进,一些地方也在开展地方性的测试评价体系建设。会议明确,无论是国家级测试评价平台还是地方性相关工作,在建设过程中都要把握以下要点:一是明确功能定位,二是立足资源整合,三是确保数据共享。
【内容来源】中国钢铁新闻网
【版权声明】版权归原作者所有,如有侵权请联系删除
【编辑】侯思璇
